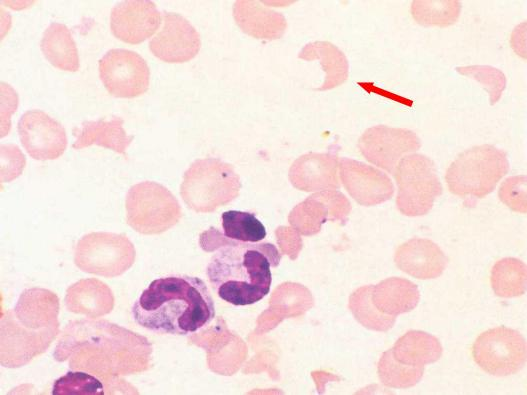

【第一百三十七期】基层检验网形态学培训
【第一百三十七期】基层检验网形态学培训
每周一次,每次几张,只要您坚持来,抽出几分钟的时间,相信您的识图能力会不知不觉的提升哦
1、请识别下图箭头所指细胞名称。外周血涂片, 瑞氏染色, 10×100倍):
答案:盔形红细胞 (裂红细胞、破碎红细胞)
解析:该类破碎红细胞 , 形似头盔。外周血检出盔形、三角形等裂红细胞 , 同时伴有其他形态的破碎红细胞 , ﹥3%有重要诊断意义 ,部分病例可高达 50%(参 考区间<1%)。 多见于弥散性血管内凝血、微血管病性溶血性贫血、血栓性血小板 减少性紫癜等疾病 。在 一般外周血镜检中 , 发现该类异形红细胞 , 应及时报告临 床其形态特征及比例 , 便于临床医生结合患者其他实验室检查及体征做出合理的诊治。
2、请识别下图箭头所指细胞名称骨髓涂片, 瑞氏染色, 10×100倍):

答案:柴捆细胞 (异形早幼粒细胞)
解析:该类细胞形态特征明显 , Auer 小体易见 , 呈“柴捆状”。急性早幼粒细 胞白血病 (APL) 患者骨髓中常以颗粒增多的异常早幼粒细胞增生为主 。颗粒增多 的异常早幼粒细胞形态特点为胞体大小不 一 , 胞核不规则 , 染色质粗细不等 , 胞 质量丰富 , 含大量密集紫红色嗜天青颗粒 , 无颗粒之外浆呈伪足状突出 。柴捆细胞是 APL 骨髓细胞形态中较典型的形态特征。
3、请识别下图箭头所指细胞名称骨髓涂片, 瑞氏染色, 10×100倍):

答案:异形早幼粒细胞
解析:该类细胞除具有异形早幼粒细胞基本特征外 , 核呈蝴蝶形或称凤梨形、屁瓣形等。
急性早幼粒细胞白血病骨髓细胞形态中 , 该类核畸形变形态特征典型 , 在形态学 识别中具有重要的诊断及鉴别诊断价值。
4、请识别下图箭头所指细胞名称骨髓涂片, 瑞氏染色, 10×100倍):

答案:骨髓转移癌细胞
解析:低倍镜观察可见呈片分布的细胞团 , 骨髓正常造血细胞较少见。油镜 观察可见转移癌细胞排列致密 , 甚至重叠 , 整个癌细胞团可呈桑椹状; 胞体大小 不 一 , 形态不规则; 浆多 , 色兰; 核染色质呈粗块状或粗网状 , 部分细胞可见明显核仁。
5、请识别下图箭头所指物名称骨髓涂片, 瑞氏染色, 10×100倍):

答案:杜氏利什曼原虫 (利杜体)
解析:利杜体呈椭圆形 (船形) , 有紫红色的大核和动基体 , 利杜体的动基体呈杆状 , 着色很深 , 像放在船尾的一把黑伞。利杜体与马尔尼菲篮状菌形态鉴别 , 后者菌体呈长椭圆形 , 有 一大 一小紫红 色核 , 两核间有纵隔 , 像一条河将菌体隔成一大一小的岛屿 , 称“ 一河两岸”。早 期菌体稍小呈卵圆形 , 核小偏于 一侧 , 呈紫红色 , 浆兰色 , 一侧染色很浅 , 近似 白色 , 镜下看菌体似斗鸡眼 , 所以“ 一河两岸” ,“斗鸡眼”基本概括了马尔尼菲篮状菌的形态特征。
利杜体与荚膜组织胞浆菌鉴别 ,后者胞核占胞体 1/3- 1/2 ,部分孢子的胞壁较厚 , 使其周围形成不着色的薄的空晕 , 形似荚膜。
感谢:重医大附一院检验科和合川区检验质控中心提供的内容。


